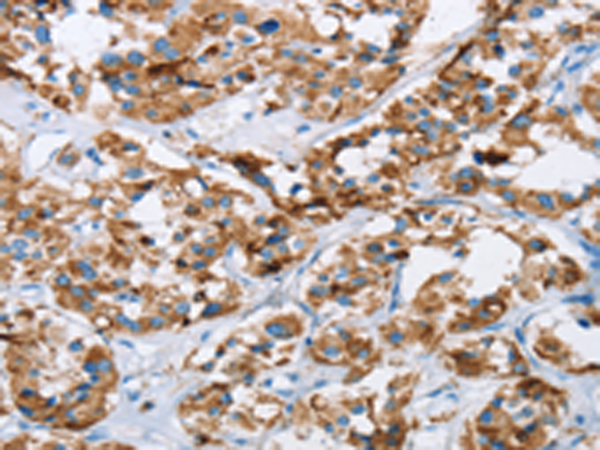

英文名稱: Anti-HINT2 rabbit polyclonal antibody
抗 原: HINT2
宿 主: Rabbit
反應種屬: Human, Mouse
標 記 物: Unconjugate
技術(shù)規(guī)格
|
Background: |
Hint2 (histidine triad nucleotide binding protein 2), also known as HIT-17, is a 163 amino acid secreted protein that contains one HIT domain, a histidine triad that has catalytic activity toward the -phosphate of ribonucleotides. Via its HIT domain, Hint2 is thought to function as a hydrolase that is encoded by a gene which maps to chromosome 9. Chromosome 9 contains 145 million base pairs and comprises 4% of the human genome, encoding nearly 900 genes. Hereditary hemorrhagic telangiectasia and Familial dysautonomia are both associated with chromosome 9. Notably, chromosome 9 encompasses the largest interferon family gene cluster. |
|
Applications: |
ELISA, IHC |
|
Name of antibody: |
HINT2 |
|
Immunogen: |
Fusion protein of human HINT2 |
|
Full name: |
histidine triad nucleotide binding protein 2 |
|
Synonyms: |
HIT-17 |
|
SwissProt: |
Q9BX68 |
|
ELISA Recommended dilution: |
2000-5000 |
|
IHC positive control: |
Human thyroid cancer and human cervical cancer |
|
IHC Recommend dilution: |
50-200 |

購物車
幫助
021-54845833/15800441009
